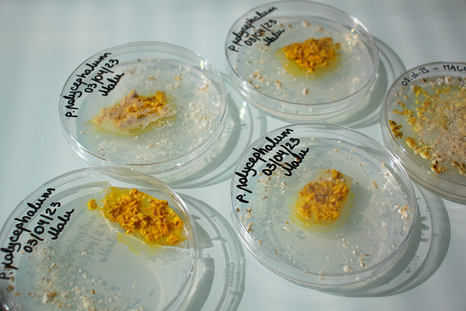

Venez découvrir le blob !
Le 28 mai de 12h30 à 14h, l'espace Biologie / Chimie mettra à l'honneur le blob !
Venez observer ce mystérieux organisme, et repartez avec votre souche si vous le souhaitez.
Au programme
- Observez-le au microscope
- Apprenez des informations insolites à son sujet
- Regardez-le se déplacer en timelapse
- Découvrez les différentes souches que nous possédons
- Apprenez à les nourrir et à vous en occuper
- Et partez avec votre propre souche si vous le souhaitez